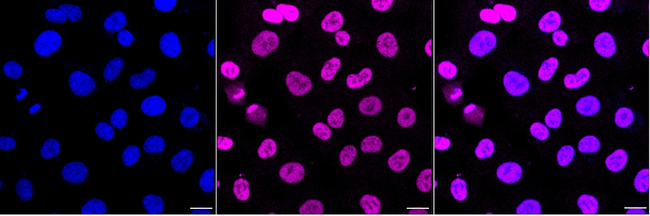
RUNX1/RUNX2/RUNX3 Antibody in Immunocytochemistry (ICC/IF)

Search
Invitrogen
RUNX1/RUNX2/RUNX3 Recombinant Rabbit Monoclonal Antibody (23GB4800)
{{$productOrderCtrl.translations['antibody.pdp.commerceCard.promotion.promotions']}}
{{$productOrderCtrl.translations['antibody.pdp.commerceCard.promotion.viewpromo']}}
{{$productOrderCtrl.translations['antibody.pdp.commerceCard.promotion.promocode']}}: {{promo.promoCode}} {{promo.promoTitle}} {{promo.promoDescription}}. {{$productOrderCtrl.translations['antibody.pdp.commerceCard.promotion.learnmore']}}
图: 1 / 4
RUNX1/RUNX2/RUNX3 Antibody (MA5-53808) in ICC/IF




产品信息
MA5-53808
种属反应
宿主/亚型
Expression System
分类
类型
克隆号
抗原
偶联物
形式
浓度
规格
纯化类型
保存液
内含物
保存条件
运输条件
RRID
靶标信息
Core binding factor (CBF) is a heterodimeric transcription factor that binds to the core element of many enhancers and promoters. The protein encoded by this gene represents the alpha subunit of CBF and is thought to be involved in the development of normal hematopoiesis. Chromosomal translocations involving this gene are welldocumented and have been associated with several types of leukemia. Three transcript variants encoding different isoforms have been found for this gene.
仅用于科研。不用于诊断过程。未经明确授权不得转售。
篇参考文献 (0)
生物信息学
蛋白别名: Acute myeloid leukemia 1 protein; Acute myeloid leukemia 2 protein; Acute myeloid leukemia 3 protein; acute myeloid leukemia gene 2; AKV core binding factor; aml1; AML1-ETO fusion; AML1-ETO fusion protein; AML1-EVI-1 fusion protein; CBF-alpha-1; CBF-alpha-2; CBF-alpha-3; core binding factor alpha 1; core binding factor alpha 2; core binding factor alpha 3; core-binding factor runt domain alpha subunit 2 (acute myeloid leukemia 1 oncogene); Core-binding factor subunit alpha-1; Core-binding factor subunit alpha-2; Core-binding factor subunit alpha-3; core-binding factor, runt domain, alpha subunit 1; core-binding factor, runt domain, alpha subunit 2; core-binding factor, runt domain, alpha subunit 3; mutant RUNX1; Oncogene AML-1; Oncogene AML-2; Oncogene AML-3; OSF-2; Osteoblast-specific transcription factor 2; PEA2 alpha C; PEA2-alpha A; PEA2-alpha B; PEA2-alpha C; PEBP2 alpha A; PEBP2 alpha C; PEBP2-alpha A; PEBP2-alpha B; PEBP2-alpha C; Polyomavirus enhancer-binding protein 2 alpha A subunit; Polyomavirus enhancer-binding protein 2 alpha B subunit; Polyomavirus enhancer-binding protein 2 alpha C subunit; runt domain, alpha subunit 1; runt domain, alpha subunit 2; runt domain, alpha subunit 3; runt related transcription factor 1; runt related transcription factor 2; Runt related transcription factor 3; Runt-related transcription factor 1; Runt-related transcription factor 2; Runt-related transcription factor 3; RUNX 2; RUNX-2; RUNX1 with skipped exon 5; SL3-3 enhancer factor 1 alpha A subunit; SL3-3 enhancer factor 1 alpha B subunit; SL3-3 enhancer factor 1 alpha C subunit; SL3/AKV core-binding factor alpha A subunit; SL3/AKV core-binding factor alpha B subunit; SL3/AKV core-binding factor alpha C subunit; transcription factor AML2; transcription factor AML2/CBFA3; unnamed protein product
基因别名: AML1; AML1-EVI-1; AML2; AML3; AMLCR1; Cbf; CBF-alpha-1; CBF-alpha-2; CBF2alpha; Cbfa-1; CBFA1; CBFA2; CBFA3; CCD; CCD1; CLCD; EVI-1; LS3; OSF-2; OSF2; PEA2aA; PEBP2A; Pebp2a1; Pebp2a2; PEBP2A3; PEBP2aA; PEBP2aB; PEBP2aC; PEBP2alpha; Pebpa2a; Pebpa2b; RUNX1; RUNX2; RUNX3
UniProt ID: (Human) Q01196, (Human) Q13950, (Human) Q13761, (Rat) Q63046, (Mouse) Q08775, (Mouse) Q64131
Entrez Gene ID: (Human) 861, (Human) 860, (Human) 864, (Rat) 50662, (Mouse) 12394, (Rat) 367218, (Mouse) 12393, (Mouse) 12399, (Rat) 156726